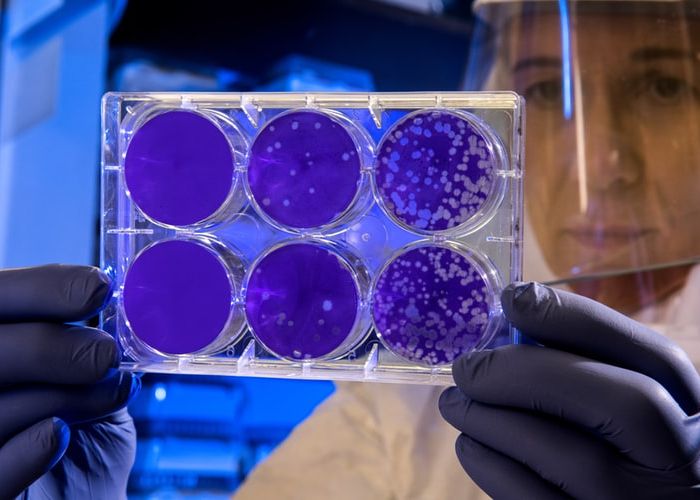

Cum poate „infecta” coronavirusul un software de calculator sau smartphone
Experții în securitate cibernetică avertizează că unii hackeri încearcă să profite de interesul oamenilor față de epidemia de coronavirus.
Astfel, hackerii trimit victimelor linkuri și fișiere aparent obișnuite, cu informații despre virus, dar care conțin un cod malițios, care poate infecta un telefon sau un calculator.
În momentul în care aceste fișiere sunt deschise sau descărcate în aparat, hackerii vor primi acces la dispozitiv, astfel încât pot să copieze sau să distrugă toate datele personale. Multe fișiere care conțin cod malițios au forma unor PDF-uri sau video MP4.
Anton Ivanov, analist cibernetic la Kaspersky, precizează că deja au apărut primele victime ale acestor hackeri care profita de dorința oamenilor de a citi informații despre coronavirus. Problema a fost recunoscută și de reprezentanți ai Facebook, Twitter și Google.
Singura soluție pentru a ne proteja telefoanele și calculatoarele de acest sistem de fraudă este să accesăm doar documente de la surse autorizate, oficiale.
De asemenea, trebuie să ne uităm cu atenție la denumirea extensiei pe care o are documentul. Astfel, fișierele care nu se termină în .docx., .pdf sau .mp4 sunt în mod clar suspecte și nu trebuie accesate.
Totodată, experții ne avertizează să nu deschidem fișiere video care au fost făcute în formatele .exe sau .Ink.
Până în acest moment, coronavirusul apărut în China a infectat peste 10.000 de oameni din întreaga lume și a provocat 213 decese.